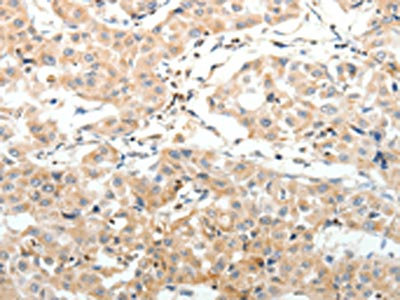

SV2A Antibody
-
中文名稱:SV2A兔多克隆抗體
-
貨號:CSB-PA117413
-
規格:¥1100
-
圖片:
-
The image on the left is immunohistochemistry of paraffin-embedded Human liver cancer tissue using CSB-PA117413(SV2A Antibody) at dilution 1/25, on the right is treated with synthetic peptide. (Original magnification: ×200)
-
The image on the left is immunohistochemistry of paraffin-embedded Human lung cancer tissue using CSB-PA117413(SV2A Antibody) at dilution 1/25, on the right is treated with synthetic peptide. (Original magnification: ×200)
-
-
其他:
產品詳情
-
Uniprot No.:
-
基因名:
-
別名:KIAA0736 antibody; OTTHUMP00000014065 antibody; SV2 antibody; Sv2a antibody; SV2A_HUMAN antibody; Synaptic vesicle glycoprotein 2 antibody; Synaptic vesicle glycoprotein 2A antibody; Synaptic vesicle protein 2a antibody
-
宿主:Rabbit
-
反應種屬:Human,Mouse,Rat
-
免疫原:Synthetic peptide of Human SV2A
-
免疫原種屬:Homo sapiens (Human)
-
標記方式:Non-conjugated
-
抗體亞型:IgG
-
純化方式:Antigen affinity purification
-
濃度:It differs from different batches. Please contact us to confirm it.
-
保存緩沖液:-20°C, pH7.4 PBS, 0.05% NaN3, 40% Glycerol
-
產品提供形式:Liquid
-
應用范圍:ELISA,IHC
-
推薦稀釋比:
Application Recommended Dilution ELISA 1:2000-1:5000 IHC 1:25-1:100 -
Protocols:
-
儲存條件:Upon receipt, store at -20°C or -80°C. Avoid repeated freeze.
-
貨期:Basically, we can dispatch the products out in 1-3 working days after receiving your orders. Delivery time maybe differs from different purchasing way or location, please kindly consult your local distributors for specific delivery time.
-
用途:For Research Use Only. Not for use in diagnostic or therapeutic procedures.
相關產品
靶點詳情
-
功能:Plays a role in the control of regulated secretion in neural and endocrine cells, enhancing selectively low-frequency neurotransmission. Positively regulates vesicle fusion by maintaining the readily releasable pool of secretory vesicles.; (Microbial infection) Receptor for the C.botulinum neurotoxin type A2 (BoNT/A, botA); glycosylation is not essential but enhances the interaction. Probably also serves as a receptor for the closely related C.botulinum neurotoxin type A1.
-
基因功能參考文獻:
- Botulinum neurotoxin type A inhibits synaptic vesicle 2 expression in breast cancer cell lines. PMID: 26339411
- SV2A expression in the bladder urothelium increases after BoNT-A injection. PMID: 26241848
- the way LEV analogues may interact with SV2A PMID: 25692762
- agents that act on the conformation of SV2A might hold great potential in the search for new SV2A-based anticonvulsant therapies PMID: 23530581
- The newly identified galactose transport capability of SV2A may have an important role in regulating/modulating synaptic function. PMID: 25326386
- The SV2A/FE65 interaction might play a role in synaptic signal transduction. PMID: 24284412
- In classical mesial temporal sclerosis 1A, the expression of SV2 isoforms is altered with a marked decrease of SV2A paralleling synaptic loss. PMID: 23617838
- High SV2A expression is associated with breast cancer. PMID: 23244111
- This study in the German population provides evidence, at a genetic level, for the involvement of the SV2A gene region in schizophrenia. PMID: 23017826
- Data report a combined modelling and mutagenesis study that successfully identifies another 11 residues in synaptic vesicle protein 2A that appear to be involved in ligand binding. PMID: 21936812
- expression of SV2A in tumor and peritumoral tissue is correlated to the clinical response to levetiracetam and predicts levetiracetam efficacy PMID: 21795655
- the role of SV2A in epileptogenesis in patients with glial tumors is questionable PMID: 20167814
- We found no association between genetic variation in SV2A and response to levetiracetam or epilepsy predisposition PMID: 18977120
- The pattern of SV2A immunoreactivity with reduced neuropil expression and altered cellular and subcellular distribution suggests a possible contribution of SV2A to the epileptogenicity of these malformations of cortical development. PMID: 19220410
- Botulinum toxin type A (BTA) inhibits the growth of LNCaP human PCa cells in vitro and in vivo. BTA acts on the cells by virtue of the BTA receptor, the SV2 protein. PMID: 19399787
顯示更多
收起更多
-
亞細胞定位:Cell junction, synapse, presynapse. Cytoplasmic vesicle, secretory vesicle, synaptic vesicle membrane; Multi-pass membrane protein.
-
蛋白家族:Major facilitator superfamily
-
數據庫鏈接:
Most popular with customers
-
-
YWHAB Recombinant Monoclonal Antibody
Applications: ELISA, WB, IHC, IF, FC
Species Reactivity: Human, Mouse, Rat
-
Phospho-YAP1 (S127) Recombinant Monoclonal Antibody
Applications: ELISA, WB, IHC
Species Reactivity: Human
-
-
-
-
-